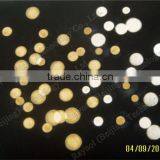
2016 Professional Q Switch Nd YAG Laser Tattoo Removal Machine for Sale thumbnail-5

2016 Professional Q Switch Nd YAG Laser Tattoo Removal Machine for Sale
2016 Professional Q Switch Nd YAG Laser Tattoo Removal Machine for Sale
Laser Tattoo Removal Machine Basic Principle
Laser Tattoo Removal Machine Therapy of epidermis and dermis pigmentation- Utilizing the explosive effect of the Laser Tattoo Removal Machine, the laser permeates the epidermis into the dermis which includes amount of pigment mass. Since the laser pulses in nanosecond but with super high energy (single pulse can reach to 2000mj), the shot pigment mass swell quickly and break into small pieces, which will be eliminated through metabolic system.
Laser Tattoo Removal Machine Therapy of the dilatation of capillary vessel- Utilizing the heat effect of the Laser Tattoo Removal Machine , the laser is absorbed by the hemachrome in the capillary vessel, then the capillary vessel become blocked and disappear.
Carbon Therapy Laser, spreading enough activated carbon particles on skin surface and make sure infiltrating pores, is using 1055nm laser to comminuting epidermis pigment based on bursting activated carbon particles; Meanwhile stimulate collagens regeneration and accelerate the skin metabolism. Therefore soft laser can reach perfect result for speckle removal, wrinkle removal, pore refining and skin rejuvenation.
Laser Tattoo Removal Machine Treatment Range
1. Pigment Removal
2. Laser Tattoo Removal
3. Freckle Removal
4. Vascular Removal
5. Wrinkle Removal
6. Pore Refining
7. Skin Rejuvenation
8. Acne Removal
9. Birthmark Removal
10. Mole Removal
11. Nevus of Ota Removal
Laser Tattoo Removal Machine Advantages
1. Professional Dr. use Nd:YAG Laser Tattoo Removal Machine
2. Active Q Switch Nd:YAG Laser Tattoo Removal Machine. Not passively Nd:YAG KTP laser tattoo removal machine
3. No pigment, no scar and no blisters
4. Combined 1064nm, 1055nm and 532nm in 1 machine
5. Spot size adjustable
6. In-motion technology as 10Hz
7. Red aiming beam available
Laser Tattoo Removal Machine Technical Parameters
Wavelength | 1064nm/532nm (1055nm) |
Laser Type | Q Switched Nd:YAG Laser |
Energy | 200-2000mj Adjustable |
Spot Size | 2-8mm Adjustable |
Aiming Beam | Red Light |
Pulse Width | ≤6ns |
Cooling System | Water Cooling+Air Cooling |
Frequency | 1-10Hz |
Interface | 8.4'' Color Touch Screen |
Dimension | 430*770*870mm |
Net Weight | 48Kg |
Power Supply | 220/110V; 50/60Hz |
Before & After
Laser Tattoo Removal Machine Testing Tools
Raynol (Beijing) Technology Co., Ltd. is a supereminent professional manufacturer, which specialized in medical & beauty Laser devices such as Q-switch Nd:YAG Laser Tattoo Removal Machine, IPL Machine, E-light Machine, RF Machine, Fractional Co2 Laser, 808nm Diode Laser Hair Removal Machine, Fat Freezing Cryolipolysis Machine, IPL SHR Laser, RBS Spider Vein Removal Machine, Fractional RF Microneedle, Laser Hair Growth Machine and Cavitation Slimming Machine etc.

Send Inquiry to This Supplier
You May Also Like
-
High Energy Density Professional Photoboimodulation Device, LED Light Whole Body Therapy MachineNegotiableMOQ: 1 Set
-
Advanced Can Dela Alexandrite Ndyag Laser Hair Removal Machine 1064nm 755nm Lazer Hair Reduction Beauty EquipmentUS$ 3700 - 6500MOQ: 1 Piece
-
Body Slimming and Shaping Beauty DeviceUS$ 800 - 800MOQ: 5 Pieces
-
Portable SHR IPL Intense Pulsed Light Laser Elight Skin Tightening Beauty Equipment With 1-10Hz High FrequencyUS$ 1 - 3000MOQ: 1 Set
-
Express AFT Vascular Remove Intense Pulsed Light PortableUS$ 1 - 10,000MOQ: 1 Set
-
2016 New Style Globalipl Jet Skin Whitening Wrinkle Removal Oxygen Facial Machines Skin MoisturizingUS$ 1 - 10,000MOQ: 1 Set
-
Diode Laser 3 Wavelength 755nm/808nm/1064nm for All Skin Types 808 nm Diode Machine Laser Hair RemovalUS$ 2000 - 4000MOQ: 1 Set
-
ADM Four Wavelengths 755 808 1064nm Diode Laser Beauty Machine for All Skin Types 808nm Diode Laser Hair Removal MachineUS$ 1750 - 2750MOQ: 1 Piece
-
2025 New 808nm 755nm 1064nm Diode Laser Hair Removal Machine 3 Wavelength Permanent Ice Professional Laser Diode 808nmUS$ 1500.00 - 3000.00MOQ: 1 Unit
-
Vertical Fractional CO2 Laser Beauty Equipment for Salon and Clinic With CE Approved CO2 Fractional Skin RejuvenationUS$ 900.00 - 1000.00MOQ: 1 Set